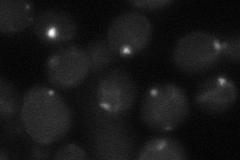
YPR128C
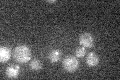
YPR128C

View description
Peroxisomal adenine nucleotide transporter; involved in beta-oxidation of medium-chain fatty acid; required for peroxisome proliferation
Localization:
Intensity:
Fold change:
Significance:
-
C’ GFP library in SD

punctate21.19 -
N' NOP1pr-GFP in SD

punctate145.325 -
N' TEF2pr-mCherry in SD

punctate,mitochondria73.2066 -
N' NATIVEpr-GFP in SD

punctate27.9889 -
N' TEF2pr-VC and Cyto-VN in SD
punctate27.1828 -
C’ GFP library in SD+DTT

punctate18.720.88No -
C’ GFP library in SD+H2O2

punctate21.61.01No -
C’ GFP library in Starvation Media
punctate17.630.83Yes -
C’ GFP library on the background of Pup2-DaMP

punctate -
C’ GFP library on the background of CCT mutant

punctate17.26520.814634No
